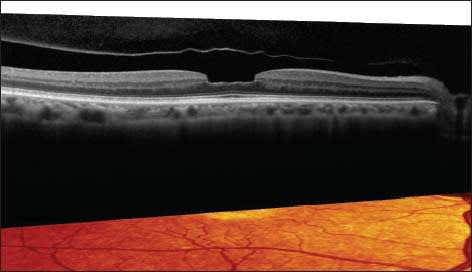

OCT Moves Into the Refractive Arena
Its uses keep multiplying, making it a must-have, proponents say.
By René Luthe, Senior Associate Editor
While OCT has long since proved itself in the retinal arena, it has also been steadily advancing as a valuable tool for the refractive surgeon. In fact, proponents increasingly view it as a device that plays a crucial role in delivering improved patient safety and avoiding the wrong surgical candidates. Here are their views on why OCT may be in every refractive surgeon's future.
For Refractive Cataract Surgery Practice
For those ophthalmologists who seek to offer their cataract patients postop emmetropia in addition to clear media, OCT is becoming invaluable.
“In a cataract surgery where a refractive component is also performed, OCTs play an enormous role,” says Amin Ashrafzadeh, MD, of Modesto, Calif. He began implanting multifocal IOLs in 2005 and incorporated OCT into his presurgical evaluations from the start. “The main issue is confirming prior to the surgery whether the eye is capable of functioning perfectly. You have to know if the macula is normal.” An essential part of the macular evaluation is an OCT scan, he says. There is simply not an adequate substitute.
Steven Safran, MD, of Lawrenceville, NJ, agrees. “It's not a good idea to implant a multifocal lens without knowing the status of the macula.” He says that in his referral cataract surgery practice, he sees many patients who are unhappy with the outcome of their premium lens surgery because of issues related to the ocular surface and macula. These are mostly avoidable problems. Checking for corneal and macular issues, he says, is a must.
The patient may have an undiagnosed macular issue that is virtually impossible to see on ophthalmoscopy, he says, “but OCT will pick it up in a heartbeat.” (Figures 1-3) OCT can now provide anterior segment information that may be invaluable in gaining insight into why patients may not be happy with their outcomes from surgery.

Figure 1. Vitreomacular traction: One sees almost nothing unusual on exam but there is impressive pathology on OCT.
Dr. Ashrafzadeh concurs on OCT's sensitivity in detecting subtle details such as a vitreomacular traction, lamellar holes or an epiretinal membrane that may not be obvious in an exam. Additionally, a cataract may be so dense that the surgeon cannot see the fundus with sufficient clarity.

Figure 2. Epiretinal membrane that is barely noticeable on exam with very impressive changes in macular architecture. FIGURES 1-3 COURTESY OF STEVEN SAFRAN, MD.
According to Farrell “Toby” Tyson, MD, of Cape Coral, Fla., epiretinal membranes are “the number one thing” OCT can help the ophthalmologist find before cataract surgery. “The patient could have perfectly normal vision, and if there is an epiretinal membrane and you do the surgery, you may get some increased retinal edema, which takes longer to heal. The patient will feel that you should have picked that up beforehand.” If OCT reveals epiretinal membranes, one can avoid implanting a multifocal lens in that patient and instead go with an accommodating lens or a monofocal.
Figure 3. Lamellar macular hole: Again, slit lamp exam is virtually normal but OCT picks up a lamellar macula defect.
Protecting the Patient, Protecting Yourself
OCT's ability to help the surgeon avoid trouble for himself, as well as his patient, makes it an invaluable aid, Dr. Safran agrees. “The problem you find before surgery is the patient's problem; the problem you find after surgery is your problem.”
Market realities also add to the pressure to use OCT in refractive procedures.
Dr. Tyson contends that OCT is a necessary tool for both refractive cataract surgery and refractive surgery. With procedures such as LASIK being elective, patients/customers expect perfection. “In today's marketplace, the expectations are so high that if for any reason you missed something, the patient is going to take it out on you,” Dr. Tyson explains. “So what you are really doing is making sure that you are seeing what all the potential problems may be down the road and you are educating patients on what their expectations should be.” Should a problem develop later, the OCT gives the surgeon proof that it was not present at the time of the procedure.
Dr. Safran sums it up: “Once you begin using OCT, you realize what dangers lurk in the jungle.”
Other surgeons concur that the information the OCT provides is also a valuable educational aid for the patient. Dr. Ashrafzadeh finds that it helps the surgeon to explain why the premium IOL a patient may have his heart set on is not the appropriate option for him. “Many times I've had to say to a patient, ‘This is not the best treatment for you, although it's a wonderful therapy. But unfortunately, you are not one who will receive the best results.'” Often the patient is so pleased with the thorough way that they were evaluated, and the frank discussion of the results, that they have referred friends and family to him.
Daniel Durrie, MD, of Overland Park, Kan., agrees about the educational value of OCT in the refractive surgery practice. He keeps OCT software in the exam rooms. “I can show patients the retina and educate them about the layers of the retina and why it's important to get good nutrition. It's part of my wellness exam.”
What You Should Look For
Dr. Ashrafzadeh offers some tips on just what cataract surgeons should look for with OCT: check the RPE for any drusen, the retinal surface for epiretinal membrane or vitreomacular traction, and confirm normal morphology. “Just by looking at those basic examples, at a glance you'll know whether the patient is a suitable candidate or not.” (Figure 4).
Should any problems be detected, Dr. Ashrafzadeh continues, the patient should be called back for a full examination and a discussion of the findings, as well as how those findings may affect the outcome.
But is an OCT necessary for every case? Dr. Ashrafzadeh doesn't believe so—not if the examination shows a “squeaky-clean eye.” However, for the majority of patients, he does view an OCT as “best practice.”
“There are plenty of times when we may not see something, yet we see it on the OCT. I think having the technicians do it is a small step and it's another check on the list of making sure things are fine and it's been documented and evaluated,” Dr. Ashrafzadeh explains. “It is cheap, it's simple, it's effective, so I don't see why it doesn't get included in the checklist.”
To make the most of an OCT investment, Dr. Safran recommends careful shopping around. Talk to OCT owners to learn why they like one device over another, and try to buy the most up-to-date technology available, given the rapid pace of innovation in this product category.
Additionally, “Make sure it has the features you need or is upgradeable if necessary down the road,” he says. Most machines can now image the macula and give information about the optic nerve. Anterior segment imaging is either available or soon will be on most units, Dr. Safran notes.
OCT and the Refractive Patient
Though OCT use is not yet as prevalent here as it is in refractive cataract surgery, some leaders in the field believe that its presence is bound to grow. OCT, they claim, delivers advantages that no other diagnostic device or examination can, making LASIK safer for patients.
David Huang, MD, PhD, of Portland, Ore., routinely uses OCT to measure flap thickness in LASIK procedures. “I use it to both monitor the performance of the microkeratome and also to ensure that there is sufficient residual stromal bed in enhancement cases,” he explains. He believes this helps to safeguard against kerectasia and may help detect it.
OCT, Dr. Huang says, is vastly more accurate and convenient than the previous methods of measuring flap and epithelial thickness. Where intraoperative pachymetry requires the surgeon to lift the flap, OCT does not, he points out. Additionally, OCT offers higher resolution. “It can measure flap thickness and epithelial thickness, which you couldn't do with a slit lamp, for example, or Scheimpflug camera.” And while both OCT and intraoperative pachymetry take very little time, OCT offers far more information. “With OCT, we obtain a map. With intraoperative pachymetry, you are just measuring at one point,” Dr. Huang explains. “Obviously, you get a lot more information when you have a map of corneal thickness or measurement of epithelial thickness at many different places versus just one point.”
Dr. Durrie also contends that OCT helps to make refractive surgery safer. At his practice, he says, “We don't do elective eye surgery, whether it's corneal laser surgery or premium lens surgery, without getting a retinal OCT because it's the best way that I know of to make sure the retina is healthy.”
As for anterior segment OCT, not only is it a “beautiful way to study the cornea,” according to Dr. Durrie, it is the only way to measure epithelial thickness. This is a critical ability, he says, because the earliest sign of keratoconus is in the epithelium. As the stroma begins to stretch and move forward, he explains, the first thing that happens is that over the apex of the bulging cornea, the epithelium will thin in an effort to compensate and maintain good optics. “Before you will ever see a topography change, you will see an epithelial change.” That ability to avoid keratoconic eyes means OCT is a significant safety benefit.
Additionally, OCT enables the surgeon to find the depth of a previous LASIK flap or the depth of a scar. “I think it's better than any other device for that,” Dr. Durrie says.
Further, while obtaining epithelial thickness from current high-resolution, spectral domain OCTs remains a manual process, Dr. Durrie says that will soon change. “The devices now don't have automated thickness measurement, like they do for total corneal thickness, but those are coming. From talking to the companies, they realize that this is a great way to screen the eye and look at epithelial thickness.” He believes the addition of automated thickness measurement will make anterior-segment OCT a “have-to-have” device.

Figure 4. A 72-year-old Hispanic female seeking refractive cataract surgery wanted to be free of glasses. On preoperative OCT, vitreomacular traction was noted (top). Urged patient to plan for monofocal implants only. Post-op uncorrected distance vision 20/25. Three months postop, the patient now has a full thickness macular hole (bottom).
Not that OCT is helpful only for LASIK procedures. Dr. Huang also turns to OCT when he is going to perform phototherapeutic keratectomy on a patient in whom he suspects there will be a difference between central and peripheral epithelial thickness. “For example, somebody who has a central corneal scar has lost tissue in that central cornea. Often, thicker epithelium fills in that dip, and it is good to know how much thicker the epithelium is in the center.”
Preop OCT, he says, informs the surgeon how deep it is necessary to go and how much myopic shift may occur. Post-radial keratotomy patients, who have flat central corneas, are also good candidates for OCT, according to Dr. Huang, because the epithelium is thicker in the middle than in the periphery. “You would want to know that before you do ablation. On any type of irregular cornea that requires PTK, I would do OCT.”
Dr. Durrie expects that anterior segment OCT will only become more necessary to refractive surgeons in the future. Femtosecond lasers currently being developed for intraocular surgery have built-in diagnostic devices, most of them using OCT, he reports. “This is something that you can use to image the eye in real time and also direct your laser,” he says. He believes that OCT is becoming something that will allow surgeons to do their surgical planning “on the fly.”
“We will dock on the eye and then look at the OCT and see that this particular cornea is a little thinner.” Eventually, Dr. Durrie predicts, the new femtosecond units will not only perform lens surgery, but, given that they already make corneal incisions, they will make corneal flaps too. Bausch + Lomb recently announced an agreement to distribute the Technolas femto laser that combines both LASIK and cataract protocols in one device.
ROI and OCT
Cuts in Medicare reimbursements for OCT use may have many clinicians reluctant to shell out approximately $50,000 to $60,000 for a new device, particularly in an environment where significant cuts to the funding of Medicare in the federal budget are being discussed. Yet these surgeons contend that the return on investment for OCT is relatively quick. “OCT pays for itself in lots of ways,” Dr. Safran says. “If you do enough scans, it will cover itself with the monthly payment.”
Dr. Tyson notes that OCT's variety of applications means that reimbursement cuts are not the obstacle some might think. “You can use it with glaucoma codes, retinal codes and anterior chamber codes,” he says. He cautions, however, that not all OCT devices can perform all those functions, so be sure to do your research before investing in a model.
Since refractive surgery is an elective procedure not covered by insurance, surgeons can incorporate OCT into their presurgical evaluation. Dr. Durrie concedes that since his is a private-pay only practice, he has the liberty of merely explaining to the patient why he deems OCT a necessary part of the refractive surgery evaluation. For other types of practices, he advises speaking to billing consultants and following their recommendations.
Yet even for practices that rely on Medicare, performing OCT is important, according to Dr. Ashrafzadeh. “When we charge the patient the extra money for these multifocal implants, it has to be a reasonable charge for particular services provided,” he says. “It is clear that Medicare pays for the cataract surgery, but the up charges are up to the surgeon on a ‘reasonable' basis. And that reasonableness has to be defined and has to be identified as to what exactly they are.”
Thus the surgeon must justify components such as manifest refraction, cycloplegic refraction, corneal topographies, the extended discussions about the risks and benefits, and the extended visits postoperatively in discussing the side effects, such as glare and halo, the OCTs that may be necessary, the specular microscopy that may be needed, the laser refractive surgery or limbal relaxing incisions, Dr. Ashrafzadeh points out. “These are now value-added components that are built in. If you say part of my evaluation included examination with the OCT and its interpretation, that again upholds the reasonableness of your treatment plan and why you can charge what you charge for the premium IOLs.”
Don't Drive Without Headlights
While OCT remains a newish addition to refractive surgery, with or without lens replacement, proponents are certain both of its clinical value and of its inevitability. According to Dr. Safran, “OCT will give you a tremendous amount of information that you really can't practice without anymore. It's not just for refractive cataract surgery, it's also for being a good diagnostician when patients come in with problems after cataract surgery,” he says, then quickly amends: “Forget about that—it's useful for patients who come in with just about any clinical problem: glaucoma, cataract, neuro-ophthalmologic, retina, pre- or post surgical, you name it. If you don't do an OCT, it's like driving without headlights.” OM








